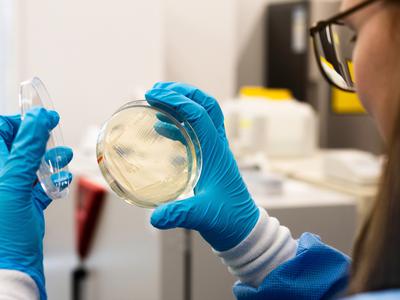
Zdravniki svarijo pred glivično okužbo: odporna je na zdravila in hitro se širi

ARTICLE AD
Poljska mora priznati zakonske zveze istospolnih parov, ki so bile sklenjene v tujini, četudi sama takšnih porok ne dovoljuje, je razsodilo sodišče EU, ki pa Poljski ne nalaga, da mora istospolne poroke uzakoniti tudi na svojem ozemlju. Gre za pomemben pravni precedens, ki bo vplival na celotno Unijo. Primer se je začel, ko sta poljska državljana, ... Več

2 hours ago
26

English (US)